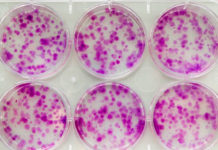

Архив
Нейроэндокринные гастроэнтеропанкреатические опухоли
Заболеваемость Нейроэндокринные гастроэнтеропанкреатические опухоли (ГЭП-НЭО) представляют собой разнородную группу опухолей, происходящих из нейроэндокринных клеток эмбриональной кишечной трубки, с наиболее частой локализацией первичного очага в слизистой...
Метастатический немелкоклеточный рак легкого (НМРЛ)
Заболеваемость Немелкоклеточный рак легкого (НМРЛ) встречается у 80-85% больных раком легкого. Развитие рака легкого связано с курением у приблизительно у 90% заболевших мужчин и у...
Мелкоклеточный рак легкого (МРЛ)
Заболеваемость Наиболее распространенной причиной смерти от онкологических заболеваний в Европе в 2006 году являлся рак легких (по оценкам, 334 800 случаев летального исхода). После рака...
Злокачественная мезотелиома плевры
Заболеваемость Злокачественная мезотелиома плевры (ЗМП) ― редкая опухоль. Заболеваемость составляет 1,25 на 100 тысяч в Великобритании и 1,1 на 100 тысяч в Германии. Предполагается, что...
Почечноклеточный рак
Заболеваемость В среднем в мире ежегодно регистрируется приблизительно 209 тыс. новых случаев заболевания ПКР, что составляет 2-3% в структуре злокачественных новообразований у взрослых. Ежегодно погибает...
Инвазивный рак мочевого пузыря
Заболеваемость В среднем заболеваемость раком мочевого пузыря в Европе составляет 19.5, а смертность ― 7.9 случаев на 100 тыс. человек в год. У 70% больных...
Рак предстательной железы
Заболеваемость Заболеваемость раком простаты в европейских странах составляет 78,9 случаев на 100 тыс. мужчин, а смертность от этой патологии ― 30,6 случаев на 100 тыс....
Смешанные и несеминомные герминогенные опухоли
Заболеваемость Заболеваемость опухолями яичка в Европе удваивается каждые 20 лет. В среднем заболеваемость раком яичка в Европе составляет 6,3 на 100 тыс. чел. мужского населения,...
Семинома яичка
Заболеваемость Заболеваемость опухолями яичка в Европе удваивается каждые 20 лет. В среднем заболеваемость раком яичка в Европе составляет 6,3 на 100 тыс. чел мужского населения,...
Хронический миелоидный лейкоз (ХМЛ)
Заболеваемость Заболеваемость в Соединенных Штатах Америки составляет 1-2 случая на 100 тыс. человек в год при отсутствии существенных географических различий. Возрастная медиана на момент диагноза составляет...